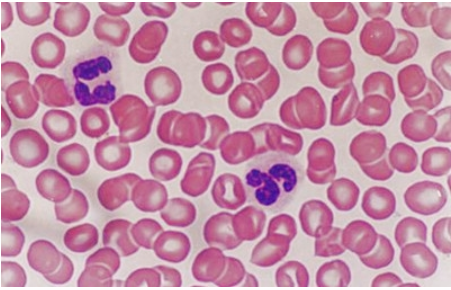
為什么寶寶中性粒細胞偏低 中性粒細胞偏低嚴重嗎 為什么寶寶中性粒細胞偏低 中性粒細胞偏低嚴重嗎

時間:2018-10-19 16:03:02來源:本站整理作者:xl點擊:
我們有時會給寶寶做血液檢查,卻發現寶寶中性粒細胞偏低,這又是怎么回事呢?中性粒細胞偏低嚴重嗎?接下來八寶網小編就和大家來說說。
中性粒細胞是在瑞氏(Wright)染色血涂片中,胞質呈無色或極淺的淡紅色,有許多彌散分布的細小的(0.2~0.4微米)淺紅或淺紫色的特有顆粒。細胞核呈桿狀或2~5分葉狀,葉與葉間有細絲相連。

中性粒細胞來源于骨髓,具有分葉形或桿狀的核,胞漿內含有大量既不嗜堿也不嗜酸的中性細顆粒,中性粒細胞具趨化作用、吞噬作用和殺菌作用。
這些顆粒多是溶酶體,內含髓過氧化酶、溶菌酶、堿性磷酸酶和酸性水解酶等豐富的酶類,與細胞的吞噬和消化功能有關。
一般中性粒細胞的正常值為0.40~0.75(40%~75%);(1.80~6.30)×109/L
1、先天性因素。如果寶寶本身體質中性粒細胞偏低,則是因為在母體中分泌發育不完全。
2、病毒感染。如果寶寶在某時間段內持續高燒不退,很有可能是感染了病毒,導致寶寶的中性細胞數量減少,無法抵抗外來病毒侵入。
3、外界環境因素影響。寶寶抵抗力會比較弱,如果生活在含鉛、貢比較多的環境,會抑制住寶寶體內中性細胞的生長。
4、貧血因素。如果寶寶貧血也會造成輕微的中性粒細胞指數偏低。

對于中性粒細胞偏低的問題,媽媽們不用太過擔心,只要恰當處理是沒有什么太大的問題的,注重平時的飲食安全,營養均衡。
網友跟帖
Copyright 2015-2020 8bb.com 〖八寶網〗 版權所有 鄂ICP備19016373號-1
聲明: 本站文章均來自互聯網,不代表本站觀點 如有異議 請與本站聯系 本站為非贏利性網站 不接受任何贊助和廣告
網友評論僅供其表達個人看法,并不表明八寶網立場。